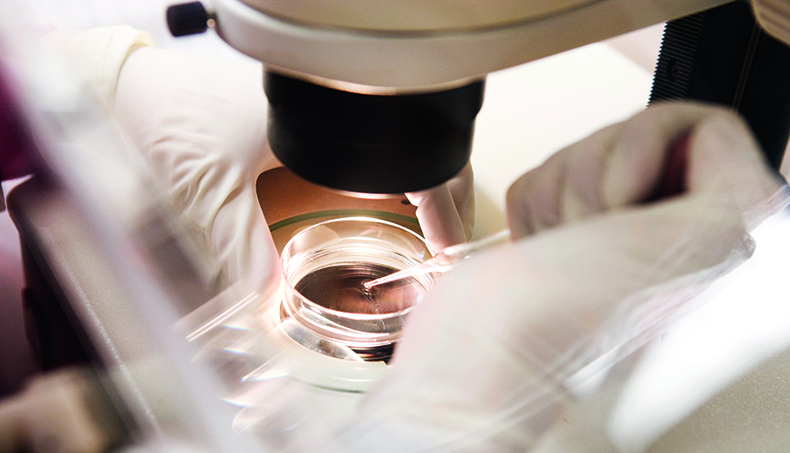

Varje arbetsgivare vet att nöjda och engagerade anställda gör ett bättre jobb. Och att sannolikheten för att de inte drar vidare ökar. Därför kan det vara värt att fundera över om det finns saker du vill ha som inte nödvändigtvis gör din plånbok fetare, men kanske ditt liv rikare.
Jobbar du dessutom i ett bristyrke finns alla möjligheter att få något extra. Och då pratar vi inte löneförmåner som lunchkuponger och bilar längre. Den arbetsgivare som vill konkurrera om den hetaste arbetskraften måste komma med betydligt mer lockande och inspirerande erbjudanden. Från småsaker som höjer trivseln på kontoret till ekonomisk hjälp.
Det kan till exempel röra sig om nya arbetsformer och ökad valfrihet kring var och när man ska arbeta. Eller så kan det handla om skattebefriade medicinska ingrepp eller möjligheten att bidra till att världen blir en aning bättre genom att få arbeta ideellt.
Kollega har hittat en handfull företag som erbjuder sina medarbetare annorlunda förmåner.
1. PROVRÖRSBEFRUKTNING
På verkstadsföretaget Alfdex i Landskrona satsar man mycket på personalförmåner. Exempelvis har de omkring 140 anställda en årlig medarbetarbonus. Men de erbjuds också provrörsbefruktning, IVF-behandling, mot bruttolöneavdrag.
– Man frågade om det fanns ett intresse hos personalen, och det fanns det, säger Isabel Ballin på Wise consulting och HR-konsult på Alfdex.
– Friskvård tillhör det som företagen kan jobba med allra mest. Det är en win-win-situation för företaget och de anställda.
För medarbetaren innebär bruttolöneavdraget en besparing på minst 30 procent av kostnaden, som handlar om tiotusentals kronor.
Alfdex erbjuder även möjlighet att låta operera synfel mot bruttolöneavdrag.
2. ÖGONLASERBEHANDLING

Resebolaget TUI erbjuder de anställda en rik flora av förmåner med allt från biobiljetter och matkasse till synfelsbehandlingar.
– Det är inte så märkligt, säger Nikolai Johnsen, tf pressansvarig för TUI Sverige.
– Vi har ambitionen att vara en av de mest attraktiva arbetsgivarna i Sverige, det är ett uttryckligt mål och gäller alla aspekter av anställningen. Då vill vi självklart också ge våra medarbetare de mest intressanta och relevanta erbjudandena som finns på marknaden.
Synfelsbehandlingen betalas via bruttolöneavdrag. För medarbetaren innebär det en besparing på minst 30 procent av kostnaden, mellan 12 000 och 60 000 kronor beroende på synfel.
3. TANDVÅRDSFÖRSÄKRING

De som jobbar på LKAB har länge haft möjlighet till billigare tandvård. 2014 beslutade företaget att höja ersättningsnivån. I dag ersätter försäkringen de första 3 000 kronorna av tandläkarbehandlingen fullt ut, därefter och upp till 10 000 kronor ersätts den anställde med 70 procent av kostnaden.
– Jag tror att det är väldigt uppskattat bland de anställda. Tandvården är dyr och har till och med blivit en klassfråga, säger Fredrik Björkenwall, kommunikatör på LKAB.
Försäkringen gäller så kallad bastandvård och innefattar alltså inte kosmetisk tandvård och implantat.
4. FILM ÄR BÄST PÅ JOBBET

När en ny säsong av Game of Thrones släpps ger det effekter i Malmö. På Topvisible, ett konsultbolag inom digital marknadsföring med åtta anställda, samlas man på måndagsmorgnar klockan åtta för att titta på de nya avsnitten tillsammans.
– Alla sitter här när man kommer till jobbet. Det känns mysigt på något vis, det är en skön stämning, säger vd:n Maria Eckerwall.
För företaget är det ingen särskilt kostsam personalförmån, däremot ger den sannolikt en hel del tillbaka genom att den skapar gemenskap. Den enda på företaget som inte fastnat för serien är Maria Eckerwall själv, ”men det beror nog mest på att jag har småbarn och dåligt med tid”.
5. VOLONTÄRARBETE

Sugen på att hjälpa andra, men har ont om tid? Då har Microsoft den rätta löneförmånen för dig. Här har de anställda rätt till tre dagars volontärarbete per år med full betalning.
– Vi ser både i våra medarbetarundersökningar och på andra sätt att den här förmånen är en bidragande orsak till att man är stolt över att jobba på Microsoft, säger HR-chefen Helena Sjöberg, som själv har volontärarbetat med att vika kläder åt Röda Korset.
Vilket slag av frivilligt arbete medarbetarna ägnar sig åt lägger sig inte arbetsgivaren i.
– Man kan göra precis vad man vill och tycker är bäst att jobba med. Vi har medarbetare som jobbar åt stora organisationer som Röda Korset, men vi har också många engagerade anställda som ger läxhjälp i Akalla, där vi har vårt kontor. Det viktiga är att det kommer från individen. Många medarbetare är eldsjälar och drar själva i gång projekt, säger Helena Sjöberg.
FOTO: COLOURBOX, SHUTTERSTOCK, ©HBO
Förmånerna som väger tyngst
Vilken är den viktigaste löneförmånen? När den frågan ställdes i en Sifoundersökning i fjol var svaret solklart: tjänstepensionen. Därefter följer i tur och ordning friskvårdsbidrag, träning på arbetstid, tjänstebil, mobiltelefon, hushållsnära tjänster och fruktkorg.
Undersökningen, som gjordes på uppdrag av organisationerna bakom Tjänstepensionens dag, visar att det framför allt är personer som fyllt 50 år som värdesätter tjänstepensionen.
Yngre föredrar i tur och ordning gym, massör, städhjälp i hemmet, personlig tränare och psykolog. Detta enligt kundtjänstföretaget Transcom, som låtit personer i åldern 18 till 30 år välja mellan ett antal förmåner som de skulle vilja erbjudas på sin framtida arbetsplats.
De 14 vanligaste förmånerna (utan inbördes ordning)
- Pensionslösningar
- Förmånsbil
- Längre semester
- Fri läkar- eller tandvård
- Försäkringar (till exempel privat sjukförsäkring)
- Subventionerade lån
- Hemservice, städning, barnpassning
- Bostad
- Friskvård
- Livsstilscoachning
- Rikskuponger, subventionerad lunch
- Parkeringsplats
- Rabatter
- Företagets produkter till lågt pris
Källa: Anna-Karin Mattsson, lönerådgivare på Unionen. Förmånerna är utan inbördes ordning